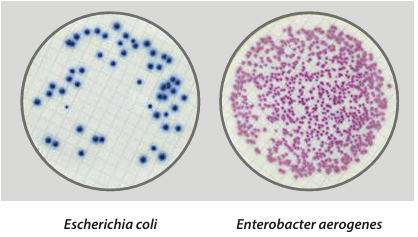
Easy Dry Chromatic Coliform ISO - Kormay Biomedicals store

Description
Chromogenic medium for detection and enumeration of E. coli and coliform bacteria in water, according to ISO 9308-1.
Liofilchem Easy DryTM are absorbent pads impregnated with a sterile, dehydrated culture medium. Each pad is preplated in a Petri dish and is immediately ready to use after pouring sterile distilled or deionized water on it. Easy DryTM are optimal for the examination of large sample volumes by the membrane filter method.
Easy DryTM Chromatic Coliform ISO is a selective and differential chromogenic medium used for the detection and enumeration of Escherichia coli and coliform bacteria in water.
This medium complies with ISO 9308-1:2014 for the examination of water samples with low bacterial background flora.
Disclaimer: This product is for laboratory use only.
Payment & Security
Your payment information is processed securely. We do not store credit card details nor have access to your credit card information.